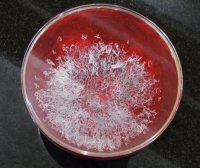
《藉心经说真谛》至宝经典法会 佛降甘露恭贺

羌佛圣迹
一共34篇文章
专题:第期
-
第三世多杰羌佛证明如来正法 神鸟点水舞
以下我们来看一非常平淡,但除了佛陀,任何大法王、大法师、大圣德都办不到的短片实况。 第三世多杰羌佛证明如来正法,凡诽谤佛陀者皆属邪师骗子 公元 2014 年 5 月 19 日下午,大约五点多钟的时候,南无第三世多杰羌佛一行在参观了墨西哥梅里达市(Merida)东边的一个玛雅古迹之后,墨西哥裔的导游在返回梅里达市的路上带领大家顺路参观一个由农场庄园改成的高级度假酒店,这个度假酒店的名字叫 Temoz…... 众善奉行
- 77
- 0
-
最高急速成就的佛法,必须用纯正的心行才能获得
真正的如来正法,把我震惊了,把大家惊醒了! 我感恩佛菩萨让我开了圣法眼界,对得起我这一生出家为尼了! 2018年农历新年前夕,我们喜气洋洋地等待格兰德谦释勒玉尊、旺札上尊、莫知尊者三位大圣德来与我们共贺新年。没想到,当时因缘突变,本来是与圣德共庆年会,竟然冒出一个巨大宏深的法缘,让我们在场的佛弟子开了无上殊胜的眼界,真的是那句话:“ 百千万劫难遭遇”啊! 当天,现场有近百位善根深厚的佛弟子,突然,…... 众善奉行
- 50
- 0
-
《藉心经说真谛》至宝经典法会 佛降甘露恭贺
▲众人在现场看到佛陀降下甘露穿过房顶和水晶钵盖进入钵中。 ▲禄东赞法王用甘露领衔的七支圣水加持《藉心经说真谛》首发纪念版的印章、印泥。 文/洛杉矶讯 《藉心经说真谛》实在是至高无上殊胜的经典,此宝书于2014年阳历3月7日,在美国圣迹寺首度举行加持法会,在法台上供奉了《藉心经说真谛》经典宝书,及由七众行人念诵修持的六部大法及圣咒和文书法水、杨枝等,前方存放了46枚准备法水加持的《藉心经…... 众善奉行
- 62
- 0
-
我亲身经历了佛陀的觉境
我释正慧佛弟子,已经回到台湾,有人看到我在五月五日请国际佛教僧尼总会帮我转发的文,文中提到“我在南无第三世多杰羌佛恩师坛场受教了十八年,这期间见闻了、体验了、听到了、感受了、历历在目,太多太多”,有人指出:“说空洞事哪个都会,为什么举不出一个实例呢?”我要说的是你可怜,太污辱出家人了,我放下专业出家为尼是为什么?难道为了打妄语遭恶报吗?我出家修行就是为了真诚快捷息除不净之业,得到修学大法在这一世彻…... 众善奉行
- 70
- 0
-
我们见到了佛陀真容发誓为证
为了利益大众请国际佛教僧尼总会为我转发这篇我愿负因果责任的文章 我们见到了佛陀真容发誓为证 我叫百哲拉母,很多人都知道我这个人,因为我曾经跟蒋贡康钦仁波且上过擂台比试过,斗过法,我输给了他,很惭愧修持欠佳,法不如人,我是一个真心诚意的修行者,我今天以担负因果责任的言行要写一篇不具任何夸张的纪实文章。2017年12月29日下午于美国洛杉矶弥陀殿,弟子百哲有幸听闻了H.H.第三世多杰羌佛说法,当时在场…... 众善奉行
- 58
- 0
-
看到H.H.第三世多杰羌佛的佛陀真容面貌
昨天2017年12月29日下午五点钟,在美国弥陀殿中,有僧众和居士四众佛教徒,皆聪慧善根深厚行人,年长者八十老人,孺幼两岁孩童聚,满场席地而坐,待后闻法,也有少许妖孽(众生)混坐于其中,大家礼拜后向羌佛奉上供养,南无羌佛一如既往照常不收分文,义务而为说法,此时有白哲仁波且合掌向佛礼请说:“我们一直以来都看到佛陀师父红光脸面,精神充沛,常人中健康者的脸色精神完全无法比拟,为什么佛陀的脸这么红润?”羌…... 众善奉行
- 35
- 0
-
南无第三世多杰羌佛的发舍利
1999年九月底有幸拜见南无第三世多杰羌佛恩师,至今即将满二十年。对一位年岁已七十三的我来说,这二十年才是此趟来到娑婆世界最主要的因缘:学习正法、弘扬正法、自觉觉他。 能预知时辰写完拜别文,墨迹未干随即坐化圆寂,了生脱死的禄东赞上尊,是我在美国拜师时所认识的师兄。因经常到出版社恭请阿王诺布帕母的佛书,而和师兄较有缘接触,也因此常受到师兄在修行学佛上的鼓励和指导,尤其是在参禅打坐方面。 有一天师兄的…... 众善奉行
- 33
- 0
-
真实佛法在人间 天乐五彩祥云起 佛降甘露成宝柱 仰谔益西诺布大法王佛诞展神威
仰谔大法王(中红衣长发者)于铁蛇年佛诞日在云集的高僧们现场观礼下请佛降真精甘露法柱的历史性珍贵镜头。 显密总持仰谔益西诺布大法王佛诞日用普通的响铜钵请佛降下甘露于钵中,堆积成上大下小的法柱,高约两英尺,同时五彩舍利亦随甘露在空中飞舞,降在法柱上。 转载自台湾立报2001年5月4日 图/文 胡鉴原 显密总持仰谔益西诺布(即南无第三世多杰羌佛。下同)之法号,全世界的佛教徒可以说是如雷贯耳,尤其是大法王…... 众善奉行
- 57
- 0
-
天降奇迹 烈日当空无滴雨 木棉树降香雨能听话
这场不平常的雨是从方圆大约一丈宽没有半片树叶的木棉树密布的枝干间落下来的,紧捱著木棉树旁的树,不论是有叶子的,还是枯枝,竟然都没有下一滴水;最神奇的是所有落下来的雨水非常密集,但却没有一滴滴在木棉树干上……... 众善奉行
- 23
- 0
-
恭迎《多杰羌佛第三世》宝书大法会 芳香甘露凌空降下观众称奇
旧金山讯 2008年6月26日,国际佛教僧尼总会21日领导百余个团体上千人在旧金山举办迎请《多杰羌佛第三世》宝书的盛会,大会由舞龙舞狮热闹登场,典礼全程庄严隆重,出现史无前例的祥瑞,典礼一宣布开始,艳阳高照、天空无雨,但圣迹境界出现,从华藏寺的后院玉兰花圣树然后寺外大门纷纷降下甘露,香甜滋润,众人惊叹神圣胜迹,吉祥昌盛的祥瑞境。 上千人在旧金山举办迎请《多杰羌佛第三世》宝书的盛会 玉兰花圣树纷纷…... 众善奉行
- 54
- 0
-
佛光沐洗华藏寺,这仅仅是看见佛光吗?
▲旧金山华藏寺身高二十一呎的阿弥陀佛座像法相庄严无比,为世所惊。(林君帆摄) (记者苏静蓉旧金山现场直击) 二○○四年十二月二十五日晚上十点多钟,在美国旧金山市中心华藏寺(Hua Zang Si)亭园内,许多身着袈裟的出家人和很多在家人,有的坐在凳子上,有的干脆席地而坐,每个人的脸都仰对着天空,双眼不停地扫际着天上低沉而浓厚的乌云。我好奇地问:“这是在做什么?”一个人小声地回…... 众善奉行
- 38
- 0